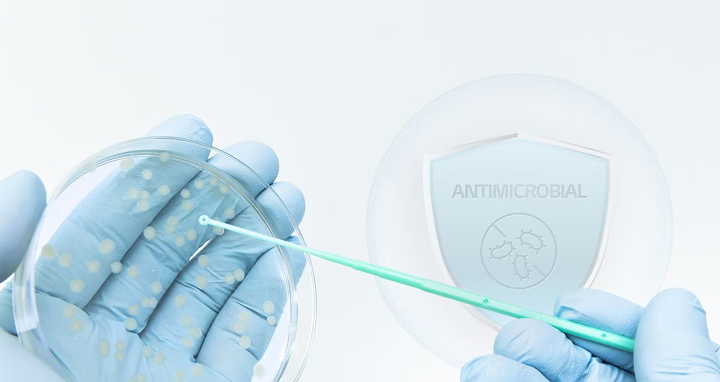
Gloved hands holding a petri dish with bacterial colonies while using a swab, with an antimicrobial shield icon in the background.

We use cookies, including cookies from third parties, to enhance your user experience and the effectiveness of our marketing activities. These cookies are performance, analytics and advertising cookies, please see our Privacy and Cookie policy for further information. If you agree to all of our cookies select “Accept all” or select “Cookie Settings” to see which cookies we use and choose which ones you would like to accept.
Antimicrobial Additive: PuroTec™
The new standard in antimicrobial glass. Our innovative solution takes surface sanitation to new heights with enhanced antimicrobial performance.